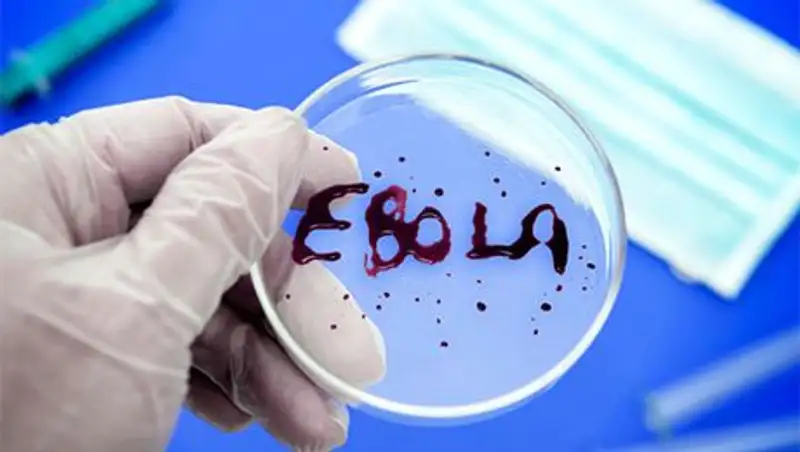
Первый больной с подозрением на лихорадку Эбола обнаружен в Бенине

Шестеро граждан Индии попали в больницу с подозрением на Эболу
 Zakon.kz
Zakon.kz
По последним данным Всемирной организации здравоохранения (ВОЗ), в странах Западной Африки жертвами вируса стали 1 тыс. 427 человек.
Шесть человек, которые прибыли сегодня в Дели (Индия) из Либерии будут помещены в госпиталь для проведения у них анализов на наличие вируса Эбола, передает РБК со ссылкой на телеканал NDTV.
Местные власти подчеркивают, что пока это только предупредительная мера. Всех прибывших в аэропорту сразу же проверяют тепловым сканером, чтоб выявить малейшие признаки заболевания. Багаж пассажиров также был временно помещен в карантин.
Вспышка лихорадки была зарегистрирована в марте в Гвинее. Позднее заболевание распространилось на Либерию и Сьерра-Леоне. В этих странах по-прежнему фиксируются новые случаи заражения. По последним данным Всемирной организации здравоохранения (ВОЗ), в странах Западной Африки жертвами вируса стали 1 тыс. 427 человек.
В понедельник в Либерии скончался врач Абрахам Борбора, которому во время лечения давали экспериментальный препарат от лихорадки Zmzpp.
Единственный, кому на данный момент удалось вылечиться благодаря Zmapp - американский врач Кент Брантли. Он заразился лихорадкой во время гуманитарной миссии в Африке, когда работал с инфицированными. Из Либерии его срочно доставили в госпиталь университета Эмори в Атланте, 21 августа его выписали из больницы.
Поделитесь новостью
Читайте также
Если вы видите данное сообщение, значит возникли проблемы с работой системы комментариев. Возможно у вас отключен JavaScript